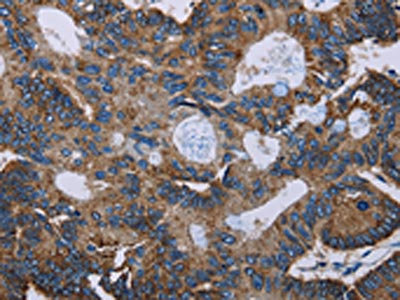

-
中文名稱:F11R兔多克隆抗體
-
貨號:CSB-PA869115
-
規格:¥1100
-
圖片:
-
The image on the left is immunohistochemistry of paraffin-embedded Human liver cancer tissue using CSB-PA869115(F11R Antibody) at dilution 1/60, on the right is treated with fusion protein. (Original magnification: ×200)
-
The image on the left is immunohistochemistry of paraffin-embedded Human colon cancer tissue using CSB-PA869115(F11R Antibody) at dilution 1/60, on the right is treated with fusion protein. (Original magnification: ×200)
-
Gel: 8%SDS-PAGE, Lysate: 40 μg, Lane 1-4: K562 cells, human kidney cancer tissue, 293T cells, HepG2 cells, Primary antibody: CSB-PA869115(F11R Antibody) at dilution 1/600, Secondary antibody: Goat anti rabbit IgG at 1/8000 dilution, Exposure time: 5 seconds
-
-
其他:
產品詳情
-
Uniprot No.:
-
基因名:
-
別名:CD 321 antibody; CD321 antibody; CD321 antigen antibody; ESTM33 antibody; F11 receptor antibody; F11R antibody; JAM 1 antibody; JAM A antibody; JAM antibody; JAM-1 antibody; JAM-A antibody; JAM1 antibody; JAM1_HUMAN antibody; JAMA antibody; JCAM antibody; Jcam1 antibody; Junction adhesion molecule 1 antibody; Junction adhesion molecule; mouse; homolog of antibody; Junctional adhesion molecule 1 antibody; Junctional adhesion molecule A antibody; KAT antibody; Ly106 antibody; PAM 1 antibody; PAM-1 antibody; PAM1 antibody; Platelet adhesion molecule 1 antibody; Platelet adhesion molecule antibody; Platelet F11 receptor antibody; PRO301 antibody; UNQ264 antibody
-
宿主:Rabbit
-
反應種屬:Human
-
免疫原:Fusion protein of Human F11R
-
免疫原種屬:Homo sapiens (Human)
-
標記方式:Non-conjugated
-
抗體亞型:IgG
-
純化方式:Antigen affinity purification
-
濃度:It differs from different batches. Please contact us to confirm it.
-
保存緩沖液:-20°C, pH7.4 PBS, 0.05% NaN3, 40% Glycerol
-
產品提供形式:Liquid
-
應用范圍:ELISA,WB,IHC
-
推薦稀釋比:
Application Recommended Dilution ELISA 1:2000-1:5000 WB 1:500-1:2000 IHC 1:50-1:200 -
Protocols:
-
儲存條件:Upon receipt, store at -20°C or -80°C. Avoid repeated freeze.
-
貨期:Basically, we can dispatch the products out in 1-3 working days after receiving your orders. Delivery time maybe differs from different purchasing way or location, please kindly consult your local distributors for specific delivery time.
-
用途:For Research Use Only. Not for use in diagnostic or therapeutic procedures.
相關產品
靶點詳情
-
功能:Seems to play a role in epithelial tight junction formation. Appears early in primordial forms of cell junctions and recruits PARD3. The association of the PARD6-PARD3 complex may prevent the interaction of PARD3 with JAM1, thereby preventing tight junction assembly. Plays a role in regulating monocyte transmigration involved in integrity of epithelial barrier. Ligand for integrin alpha-L/beta-2 involved in memory T-cell and neutrophil transmigration. Involved in platelet activation.; (Microbial infection) Acts as a receptor for Mammalian reovirus sigma-1.; (Microbial infection) Acts as a receptor for Human Rotavirus strain Wa.
-
基因功能參考文獻:
- The functional diversity of JAM-A resides to a large part in a C-terminal PDZ domain binding motif which directly interacts with nine different PDZ domain-containing proteins. (Review) PMID: 29238845
- JAM-A was expressed in all gliomas included in this study. The JAM-A intensity increased with malignancy grade, while its prognostic value was limited. PMID: 28677106
- JAM-A protein plays protective role in pathogenesis of age related diseases as Atherosclerosis, Apoplexy, thrombosis, Hypertension, Ophthalmological pathology.Short peptides Lys-Glu, Lys-Glu-Asp, and Ala-Glu-Asp-Gly could influence on F11R gene expression leading to recovery of JAM-A synthesis in cells. PMID: 28509452
- Dysregulation of JAM-A via p63/GATA-3 signaling pathway occurs in squamous cell carcinomas of the head and neck. PMID: 27036044
- JAM family members differentially regulate CXCR4 function and CXCL12 secretion in the bone marrow niche. PMID: 26866290
- Our observations suggest that increased expression of JAM-A promotes neoplasia of lung adenocarcinoma. In addition, an anti-JAM-A antibody efficiently reduced cell proliferation and provoked apoptosis, indicating the potential feasibility of JAM-A-inhibitory cancer therapy. PMID: 28837251
- a new role for CD321 in endothelial cells PMID: 29028806
- We have shown that tension on JAM-A activates RhoA to control cell stiffness. Phosphorylation of JAM-A at S284 is required for activation of RhoA and increased cell stiffness in response to tension on the protein PMID: 26985018
- Using patient-derived glioblastoma cancer stem cells, we confirmed that JAM-A is suppressed by miR-145 PMID: 26374689
- Screening of a library of human cell surface membrane proteins showed that the Hom-1 vesivirus could utilize human junctional adhesion molecule 1 as a receptor to enter cells and initiate replication. PMID: 28196955
- Our results showed that APOC3 was closely associated with the inflammatory process in ECs, and that this process was characterized by the increased expression of TNF-alpha. Inflammatory processes further disrupted the tight junctions (TJs) between HUVECs by causing increased expression of JAM-1. PMID: 27619170
- High expression of junctional adhesion molecule-A and EphB2 can predict poor overall survival and high mortality rate, and EphB2 is an independent prognostic biomarker in lung adenocarcinoma patients. PMID: 28231727
- JAM-A is one of the malignancy markers of HNSCC as well as beta-catenin in histopathology, and the plasma-soluble JAM-A may contribute to a serum diagnosis of HNSCC. JAM-A is a promising molecular target for diagnosis and therapy in HNSCC. PMID: 27115511
- F11R mrna expression was higher in rheumatoid arthritis patients, but promoter polymorphisms did not appear to be related to disease susceptibility. PMID: 26230081
- Data indicate that junctional adhesion molecule-A (JAM-A) is overexpressed in multiple myeloma (MM) cells and regulates reovirus sensitivity in MM. PMID: 26513296
- JAM-A regulates the planar orientation of the mitotic spindle during epithelial morphogenesis. It triggers transient activation of Cdc42 and PI3K, generates a gradient of PtdIns(3,4,5)P3 at the cortex and regulates the formation of the actin cytoskeleton. PMID: 26306570
- Data indicate that junctional adhesion molecule A (JAM-A) is a potential target of microRNA-495 {miR-495) in breast cancer cells. PMID: 25070379
- RNA interference mediated JAM-A gene silencing promotes human epidermal stem cell proliferation. PMID: 25471296
- JAM-A up-regulation can increase the proliferation, cytokine secretion and wound-homing ability of MSCs, thus accelerating the repair rate of full-thickness skin defects PMID: 25994236
- JAM-A promotes proliferation and inhibits apoptosis of gastric cancer, suggesting that it has a pivotal role in gastric cancer progression. PMID: 25916097
- CD14(+)CD16(+) monocytes selectively transmigrated across our BBB model as a result of their increased JAM-A and ALCAM expression. PMID: 25420915
- Junctional adhesion molecule-A, an epithelial-mesenchymal transition inducer, correlates with metastasis in nasopharyngeal cancer. PMID: 25416560
- Low JAM-A expression correlates with poor clinical outcome and promotes cell migration and invasion in gastric cancer. PMID: 25033702
- Redistribution of JAM-A in endothelial cells after stimulation with pro-atherogenic oxidized lipoproteins results in increased transmigration of mononuclear cells. PMID: 24704627
- trans-dimerization of JAM-A occurs at a unique site and with different affinity compared with dimerization in cis. Trans-dimerization of JAM-A may thus act as a barrier-inducing molecular switch that is activated when cells become confluent. PMID: 24672055
- JAM-A regulates epithelial permeability via association with ZO-2, afadin, and PDZ-GEF1 to activate Rap2c and control contraction of the apical cytoskeleton. PMID: 23885123
- the clinical significance of junctional adhesion molecule A (JAM-A) in patients with non-small cell lung cancer PMID: 24265754
- These studies establish F11R as a novel monocyte prognostic marker for GBM critical for defining a subpopulation of stromal cells for future potential therapeutic intervention. PMID: 24147027
- JAM-A(ov) MSCs migrated into the HF sheath and remodeled HF structure effectively. PMID: 24558164
- JAM-A recruits Csk to the integrin-c-Src complex, where Csk negatively regulates c-Src activation, thereby suppressing the initiation of outside-in signaling. PMID: 24300854
- The entry of HIV infected and uninfected CD14(+)CD16(+) monocytes into the brain was facilitated by significantly increased surface JAM-A, ALCAM, CD99, and PECAM-1, as compared to CD14(+) cells that are CD16 negative. PMID: 23922698
- Our data identify endothelial JAM-A as an important effector molecule integrating atherogenic conditions to direct inflammatory cell entry at predilection sites of atherosclerosis. PMID: 24065611
- Data indicate that CD9 acts as scaffold and assembles a ternary JAM-A-CD9-alphavbeta3 integrin complex from which JAM-A is released upon bFGF stimulation. PMID: 23389628
- study concludes that JAM-A is co-expressed with HER2 and associates with aggressive breast cancer phenotypes; speculate that JAM-A may regulate HER2 proteasomal degradation and activity PMID: 22751120
- Sinonasal epithelium in allergic fungal rhinosinusitis displays increased epithelial permeability and an altered expression of junctional adhesion molecule A PMID: 22927233
- Low expression of junctional adhesion molecule A is associated with metastasis in pancreatic cancer PMID: 22549289
- Suggest a prognostic and possibly a pathogenic role of JAM-A in arterial hypertension. PMID: 22918977
- Data suggest that the Reovirus type 3 Dearing (T3D) jin mutants may be useful as oncolytic agents for use in tumors in which reovirus receptor Junction Adhesion Molecule-A (JAM-A) is absent or inaccessible. PMID: 23110175
- JAM-A can interfere with tumor proliferation and suggest that JAM-A is a potential novel target in oncology. PMID: 22886345
- TGF-beta1 treatment of MCF-7 cells significantly reduced JAM-A mRNA & protein via SMAD activation, & induced cell invasion. PMID: 22647687
- findings provide compelling evidence of a novel role for JAM-A in driving breast cancer cell migration via activation of Rap1 GTPase and beta1-integrin PMID: 21429211
- de novo synthesis of F11R in endothelial cells (EC) is required for the adhesion of platelets to inflamed ECs. PMID: 21703019
- downregulation of JAM-A reduces tumor aggressive behavior by increasing cell susceptibility to apoptosis PMID: 21695058
- these data identify JAM-A and fascin as novel targets of miR-145, firmly establishing a role for miR-145 in modulating breast cancer cell motility. PMID: 20818426
- In addition to the previously reported role of F11R in the initiation of plaque formation, F11R plays also an important role in the subsequent growth of atherosclerotic plaques. PMID: 20627246
- JAM-A expressed on CD34(+) progenitor cells regulates their adhesion to platelets or inflammatory endothelium under high shear stress in vitro and after carotid ligation in vivo or ischemia/reperfusion injury in the microcirculation of mice. PMID: 20378847
- LFA-1 binding to JAM-A destabilizes the JAM-A homophilic interaction and the greater strength of the LFA-1/JAM-A complex permits it to support the tension needed to disrupt the JAM-A homophilic interaction, allowing leukocyte transendothelial migration PMID: 18849408
- Two domains in the N-terminus and 1st Ig-fold of F11R were found, through which M.Ab.F11 triggers platelet aggregation. These 2 regions form an active site within the conformation of this cell adhesion molecule. PMID: 12008956
- platelets adhere specifically to F11R of cytokine- (TNF-alpha, INF-gamma) stimulated vascular endothelial cells PMID: 12428104
- signaling through JAM-1 and alphavbeta3 is necessary for bFGF-induced angiogenesis. PMID: 12750158
顯示更多
收起更多
-
亞細胞定位:Cell junction, tight junction. Cell membrane; Single-pass type I membrane protein.
-
蛋白家族:Immunoglobulin superfamily
-
組織特異性:Expressed in endothelium, epithelium and leukocytes (at protein level).
-
數據庫鏈接:
Most popular with customers
-
-
YWHAB Recombinant Monoclonal Antibody
Applications: ELISA, WB, IHC, IF, FC
Species Reactivity: Human, Mouse, Rat
-
Phospho-YAP1 (S127) Recombinant Monoclonal Antibody
Applications: ELISA, WB, IHC
Species Reactivity: Human
-
-
-
-
-